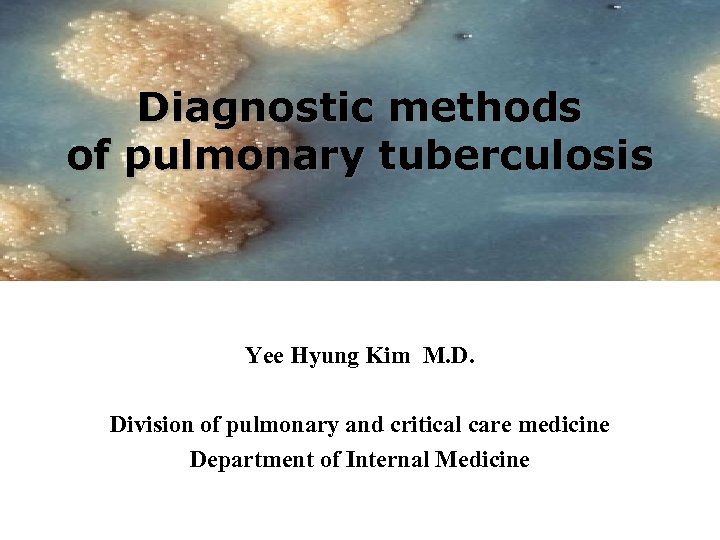
Diagnostic methods of pulmonary tuberculosis Yee Hyung Kim M. D. Division of pulmonary and

3db6fb94ea5e9e7878c4a594a0042fe9.ppt
- Количество слайдов: 62
Diagnostic methods of pulmonary tuberculosis Yee Hyung Kim M. D. Division of pulmonary and critical care medicine Department of Internal Medicine

천재로 알려진 데카르트, 칸트, 스피노자, 도스토예프스키, 발자크, 쇼팽, 이상 등은 모두 결핵으로 사망했다 Heinrich Hermann Robert Koch (11 December 1843 – 27 May 1910) “La Traviata”

New TB case notification rate 2008 결핵관리지침

TB mortality rate 2008 결핵관리지침

OECD 가입국의 결핵발생률 추계 (2002년, 29개국) 국가 결핵발생률 (/105) 도말 양성 결핵발생률 (/105) 한국 91 41 이탈리아 8 3 일본 33 15 룩셈부르크 12 6 캐나다 6 3 네덜란드 8 4 멕시코 33 15 노르웨이 6 3 미국 5 2 폴란드 32 14 오스트리아 15 7 포르투갈 47 21 벨기에 14 6 스페인 30 13 체코 13 6 스위스 8 4 덴마크 13 6 스웨덴 5 2 핀란드 10 5 슬로바키아 24 11 프랑스 14 6 영국 12 5 독일 10 4 호주 6 3 그리스 20 9 뉴질랜드 11 5 헝거리 32 14 아일랜드 13 6 아이슬란드 3 1 대한 결핵 협회

Global TB epidemic (2006, WHO) 9. 2 million new cases of TB 1. 7 million deaths of TB 대한민국은 intermediate burden of TB을 가진 나라 WHO REPORT 2008 Global Tuberculosis Control

Trend of new case notification rate per 105 by age group (2001 ~ 2005) HJ Kim, J Korean Med Assoc 2006; 49(9): 762

북한이탈주민에서의 결핵 WHO 2005년 보고 : 2003년, 인구 10만명당 184명 ( 전세계평균 140명 ) 탈북자 대상 분석 (2001. 4 ~ 2005. 12) HJ Kim, Tuberc Respir Dis 2006; 60: 285

北 충격적인 결핵 실태…北당국 이제 변해야 “北주민 최소 800만 결핵 감염”…美서 전문가 회의 열려 • 지난 11. 25일(현지시간) 미국 캠브리지에서는 “한반도의 결핵과 국 제 건강”이라는 주제로 북한의 결핵 퇴치를 모색하는 전문가 회의가 열렸다. 하바드 대학 한국학회의 김구포럼에서 주관하고 유진벨 재 단과 브리햄 여성병원, 하바드 의과대학이 공동으로 주최한 자리다. • 현재 북한 당국의 공식 입장에 따르면 북한의 결핵환자는 총 42, 591 명이다. 그러나 전문가들은 이 수치를 신뢰하지 않았다 • 한양대 의과대학 예방의학교실의 신영전 교수는 이날 “북한에서 발 간되는 보건의료 잡지 ‘인민보건’과 관련 있는 북한의 전문가는 북 한내 결핵환자 규모를 최소 8백만 명으로 추정했다”고 밝혔다.

북한이탈주민에서의 결핵 (9명의 환자에 대한 항결핵약제 감수성 결과) HJ Kim, Tuberc Respir Dis 2006; 60: 285

Classification of Mycobacterial Species M. tuberculosis complex M. bovis (우형 결핵균) M. africanum M. leprae M. avium complex (MAC) Nontuberculous mycobacteria(NTM) = atypical mycobacteria = Mycobacteria other than TB (MOTT) = environmental mycobacteria M. kansasii M. abscessus M. szulgai M. marinum M. fortuitum etc

Methods for Dx. of pulm TB • Bacteriologic methods – Sputum AFB smear & culture : Confirmative – NAA (Nucleic acid amplification) : TB-PCR • Radiologic methods – Chest PA and Lat, Chest CT • Immunologic methods – TST (Tuberculin skin test) : PPD skin test – IGRA (IFN-gamma release assay) • Quanti. FERON TB, T-SPOT. TB

폐결핵의 진단과 치료를 바라보는 관점 Radiology 중심 Bacteriology 중심 진 CXR: 활동성 여부 도말 검사, 배양 검사 단 CT 소견 PCR (분자유전학 검사) 치 방사선학적 호전 약제감수성검사: 내성 여부 (감수성, INH 내성, MDR) 료 객담 균 음전 개별화된 다양한 처방 표준화된 처방

Radiological Findings of TB Location: apical and/or posterior segment of RUL, apicoposterior segment of LUL, or superior segment of either lower lobe Infiltrate: fibronodular, irregular shadowing with variable coalescence and cavitation Cavities: thick, moderately irregular walls air-fluid levels very uncommon Volume: progressive, often rapid loss of volume within the segment(s) or lobe(s) involoved
![Sputum AFB smear (도말검사) Mycobacteria = M. tuberculosis + NTM Carbol-fuchsin stain [Ziehl-Neelsen methods] Sputum AFB smear (도말검사) Mycobacteria = M. tuberculosis + NTM Carbol-fuchsin stain [Ziehl-Neelsen methods]](https://present5.com/presentation/3db6fb94ea5e9e7878c4a594a0042fe9/image-15.jpg)
Sputum AFB smear (도말검사) Mycobacteria = M. tuberculosis + NTM Carbol-fuchsin stain [Ziehl-Neelsen methods] Auramine O stain [Fluorescence Microscopy]

Sputum AFB smear (도말검사) Mycobacteria = M. tuberculosis + NTM • Advantage – – Simple and economic High availability Rapid result reporting Identification of infectious patient • Disadvantage – Low sensitivity : 25 to 65% • Repeated examination of sputum AFB smear – Inability of differentiation from NTM species

객담 채취 횟수에 따른 균 양성률 비교 연구 도말 양성률(%) 조사 환자수 1회 2회 3회 4회 5회 Chan 1162 86 14 - - - Urbanczik 200 82 10 8 - - Blair 270 71 8 8 1 12 Levy 71 82 10 5 3 - Nair 53 68 17 2 2 11 1141 88 8 4 - - 7280 87 10 3 - - Katamba

Recommended Number of sputum AFB in the patient with suspected TB 미국 (ATS/CDC) 3회의 객담 도말과 배양검사 한국 (KCDC) 객담 검체 2개(처음 내원시 즉석 채담 1회, 그 리고 다음날 아침 집에서 기상시의 채담 1회) 를 수집하여 검사를 시행 대한 결핵 및 호흡기학회 초회 객담 도말 검사는 2회 또는 3회 실시를 원칙으로 한다 가능한 객담을 3회 채취하여 검사하는 것이 바람직하며 최소한 2회까지는 반드시 검사를 시행하여야 한다.

Sputum AFB culture (배양검사) Mycobacteria = M. tuberculosis + NTM • Media – 3% Ogawa media – Lowenstein-Jensen media – Middlebrook 7 H 10 or 7 H 11 • 4 to 8 weeks • Economic Solid Media (고체 배지)

Sputum AFB culture (배양검사) Mycobacteria = M. tuberculosis + NTM • Media – BACTEC 460 System – BACT/Alert – BACTEC 960 System • 10 to 14 days • Expensive Liquid Media (액체 배지) • 동시 접종 (미국) – 국내: 08년부터 보험인정

Advantage of AFB culture • 배양검사는 도말검사에 비해 민감도가 훨씬 높다. • 배양을 통해서만 정확한 균 동정(Identification)이 가 능하다. – 배양검사를 통해서만 폐결핵을 확진할 수 있다 • 배양이 되어야 약제감수성검사 (Drug Susceptibility Test, DST)가 가능하다.

객담 채취 횟수에 따른 균 양성률 비교 연구 배양 양성률(%) 조사 환자수 1회 2회 3회 4회 5회 500 (도말양성) 93 7 - - - 662 (도말음성) 68 32 - - - ? (도말양성) 95 4 1 - - ? (도말음성) 75 23 2 - - Blair 270 74 9 6 3 8 Levy 107 83 9 2 2 4 Nair 68 63 21 3 3 10 Chan Urbanczik 도말 양성인 경우는 반드시 배양 1 회 이상, 도말 음성인 경우에는 2 회 이상 시행하여야 하며, 객담 도말과 배양 검사를 가능하면 3회 시행하는 것이 바람직하다 (2005년 결핵 및 호흡기학회 지침)

치료 경과 및 판정에서의 균검사의 중요성 치료 실패의 정의 대한결핵 및 치료 시작 4개월 이후에도 배양 양성인 환자 호흡기학회 WHO 치료 시작 5개월 이후에 도말 양성인 환자 유럽 도말 양성 환자: 치료 시작 5개월 이후에 계속 혹은 다시 도말 양성인 환자 배양 양성 환자: 치료 시작 5개월 이후에 계속 혹은 다시 배양 양성인 환자 미국 치료 시작 4개월 이후에도 배양 양성인 환자 (치료 3개월 후에도 배양 양성인 경우는 균 음전이 느린 이유에 대해 투약의 규칙성, 약제감수성검사 등을 면밀히 검토해야)

치료에 따른 세균학적 반응 - 균 양성 환자는 매달 객담 검사를 시행 치 료 월 도말음전 S C S C S 0 +++ +++ 1 + ++ + + + 2 - + + + - - 3 - - + - - 4 - - 5 - - - 6 - - - 결과 배양음전 위음성 지속적 균배출 C S C +++ +++ +++ +++ - - + + ++ ++ - - + +++ +++ - - + ++ +++ +++ - + ++ +++ - - - ++ ++ +++ +++ +++ 치료성공 분리양성 일시적 균음전 감증현상 치료실패

AFB 도말 혹은 배양 양성이면 결핵으로 확진이 가능한가?

Classification of Mycobacterial Species M. tuberculosis complex M. tuberculosis M. bovis M. africanum M. leprae M. avium complex (MAC) Nontuberculous mycobacteria (NTM) = atypical mycobacteria = Mycobacteria other than TB (MOTT) = environmental mycobacteria M. kansasii M. abscessus M. szulgai M. marinum M. fortuitum etc

CASE I • F/53 • Chronic, Recurrent cough & sputum • TB medication (HREZ) for 2 months • Report for sputum AFB – AFB smear (2+) – AFB culture (3+) – 어디에도 M. TB 라는 말은 없다 !! 내원 당시 AFB S(2+)

CASE II 내원 당시 AFB S(2+) 2달후 AFB C(2+) 어디에도 M. TB 라는 말은 없다 !! • F/58, Abnormal CXR

Examples of Report “Mycobacterium species isolated” “AFB isolated” “Growth for AFB” “AFB Culture” M. TB라는 말은 없다 !!!. . TB vs NTM ? ?

AFB 도말 양성 검체에서 NTM의 분리비율 도말양성, 배양양성 객담 1, 328건 중 121건 삼성서울병원 1999. 1 - 2001. 12 도말양성, 배양양성 검체 719건 중 76건 서울아산병원 2002. 1 – 2002. 12 결핵연구원 검사의뢰 2000 -2001 (9. 1%) (10. 6%) 도말양성, 배양양성 검체 4, 506건 중 330건 (7. 3%) (Jeon K, et al. Int J Tuberc Lung Dis 2005; 9: 1046) (이정연 등. 결핵 및 호흡기질환 2005; 58: 385)

Methods for Identification of Mycobacteria from Culture • Morphology – rough, nonpigmented, corded colonies • Biochemical test (Conventional test) – positive niacin test – weak catalase activity that is lost completely by heating to 68 C – positive nitrate reduction test • Nucleic acid hybridization • High performance liquid chromatography (HPLC) • Nucleic acid sequencing

Methods for Identification of Mycobacteria from Culture

CASE I • F/53 • Chronic, Recurrent cough & sputum • TB medication (HREZ) for 2 months • Report for sputum AFB – AFB smear (2+) – AFB culture (3+) • M. tuberculosis complex Ag (-) – NTM Identification : M. abscessus – HREZ CRM + CIPRO + DOXY + Amk + Cefoxitin 내원 당시 AFB S(2+)

CASE II AFB S(2+), AFB C(2+) M. TB Complex Ag Test (-) NTM identification M. kansasii • F/58, Abnormal CXR

TB-PCR 검사 (Gen-Probe MTD Test & Roche Amplicor M. TB Test) 전체 (%) 도말 양성 (%) 도말 음성 (%) Sensitivity 77/80 95/96 48/53 Specificity 96/00 100 96/99 FDA recommended the use of NAA tests only for smear-positive specimen PPV 57/85 100 24/58 NPV 99 86/90 99 Enhanced version of MTD test was eventually approved by the FDA for testing respiratory specimen, regardless of the smear status

Sensitivity 99/112 88. 4% Specificity 51/51 100% Positive Predictive Value 99/99 100% Negative Predictive Value 51/64 79. 7% Tuberc Respir Dis 2004; 57; 528

TB-PCR 검사 (Real time TB-PCR test) Chae LJ, Korean J Clin Microbiol 2008; 11; 29

Algorithm Suspected Pulmonary TB in U. S. 3 sputum AFB smear & culture TB-PCR on 1 st sputum, 1 st smear-positive sputum AFB smear (+) TB-PCR (+) AFB smear (+) TB-PCR (-) AFB smear (-) TB-PCR (+) AFB smear (-) TB-PCR (-) Presumed to have M. TB Test for inhibitor Additional TB-PCR (+) Clinical Judgment No inhibitor Additional test AFB smear (+) TB-PCR (-) No inhibitor Presumed to have NTM Inhibitor present Presumed to have M. TB Additional test for TB-PCR (CDC. MMWR 2000; 49: 593)

국내 결핵 지침 (2005)에서 TB-PCR • AFB 염색이나 배양을 대치할 수는 없으며 보조적인 진단 방법으로 사용될 수 있다. • 자체적으로 제조한 in-house PCR assay을 쓰는 경우에는 방법간의 불일치가 커서 검사실의 정도 관리가 중요하다. • AFB 도말 (+)이고 PCR (+)이면 활동성 결핵으로 진단 가능 • 결핵 강력 의심 + 도말 음성인 경우, PCR (+)이면 결핵으로 진단 가능 하나 PCR (-) 이더라도 결핵의 가능성을 배제 못함. • 결핵의 가능성이 낮은 경우, 도말 양성인 경우에는 신속하게 결핵을 확인 혹은 배제하는 데 도움이 될 수 있다. • 모든 도말 양성 검체에서 TB-PCR 검사를 시행할 필요는 없다. (? )

CASE III • M/52 • Cough, sputum & dyspnea • 3차례에 걸친 TB 치료력 (+) • Report for sputum AFB – AFB smear (3+) – TB-PCR (-) 내원 당시 AFB S(3+) reactivated TB vs NTM ? ?

CASE III • M/52 • Cough, sputum & dyspnea • 3차례에 걸친 TB 치료력 (+) • Report for sputum AFB – AFB smear (3+) – AFB culture (4+) – TB-PCR (-) • M. tuberculosis Ag (-) – NTM identification : M. szulgai – CRM + RFP + EMB start 내원 당시 AFB S(3+)

Drug Susceptibility Test (DST) • • F/29 Cough & sputum for 2 mo Previous TB Hx (-) Sputum AFB 2+/4+, TB-PCR (+) DST 결과 (after 3 mo from presentation) HREZ R to INH, RFP, EMB, PZA, Sm (MDR-TB)

The emergence of resistant TB • MDR TB (Multi-drug resistant TB) – At least resistance to INH and RFP • XDR-TB (e. Xtensively drug-resistant TB) – WHO 2006. Oct – MDR-TB 이면서 + any FQs (Ofx, Lfx, Mfx, or Gfx) + at least one of 3 injectable 2 nd-line drugs (capreomycin, kanamycin, amikacin) • These resistant strains are created by human!!

Anti-TB Drug Resistance in the world - Fourth Global Report - PREVALENCE OF MDR-TB AMONG NEW AND PREVIOUSLY TREATED CASES IN THE WESTERN PACIFIC REGION, 2002– 2007.

WHO 4 th Report • The Republic of Korea and Peru have shown increasing trends in MDR-TB, any resistance and INH-resistance among new cases. • The increase in MDR-TB was statistically significant in the Republic of Korea.

Distribution of MDR TB rates among new cases (2006) Increase in Republic of Korea, Peru, Orel and Tomsk in Russia 490, 000 MDR TB cases/yr and more than 110, 000 deaths/yr On average 5. 3% of all TB cases WHO 2008, http: //www. who. int/tb

Trend of anti-TB drug resistance in Korea (1994 ~ 2004) 1994 1998 2003 2004 11. 3% 10. 9% 12. 8% INH+ 7. 7% 8. 6% 9. 9% RFP+ 2. 2% 3. 0% 3. 2% 3. 7% MDR 1. 6% 2. 2% 2. 4% 2. 7% Any resistance 54. 0% 22. 3% 28. 9% 27. 7% INH+ 45. 5% 17. 3% 24. 8% 24. 1% RFP+ 32. 3% 10. 2% 15. 8% 16. 9% MDR 27. 5% 7. 1% 13. 0% 14. 0% New cases Any resistance Retreatment Bai GH, et al. IJTLD 2007; 11: 571

Prevalence of MDR-TB in Korea Age, years New cases Retreatment cases All ages 2. 7% 14. 0% 10 -19 2. 1% - 20 -29 5. 0% 12. 5% 30 -39 2. 8% 21. 4% 40 -49 1. 5% 18. 1% 50 -59 3. 3% 4. 9% 60 -69 0. 8% 7. 4% 70 1. 1% 8. 7% Bai GH, et al. IJTLD 2007; 11: 571

TB Supranational Reference Laboratory (SRL) network, 2006 결핵연구원

DST의 정도(질) 관리가 중요!!! • MDR TB 진단 후 Relapse 되어 F/U DST 의뢰 (동일 균주) – 예) R to INH, RFP, EMB, PZA, SM, Km, Am, Ofx, RBT 여자 환자 – 결핵 연구원 (Supranational Reference Lab, SRL) : WHO에서 정도 관리 – 이외에 6개 기관이 결핵 감수성 결과를 대행 : 자체적으로 정도 관리 INH RFP EMB PZA Sm Km Am Cm Ofx Mfx Pto Cs RBT PAS S RL R R R R S S R S G 사 R R R S R R

Extensively drug-resistant tuberculosis as a cause of death in patients co-infected with tuberculosis and HIV in a rural area (Kwa. Zulu Natal), South Africa 2005. 1 ~ 2006. 3 MDR (n=221, 39%) XDR (n=53, 6%) • 55% : new cases • 67% : recent hospital admission • 83% : coinfection with HIV • 98% : died (52/53) • 85% : similar strain on genotyping 16 Neel RG, Lancet 2006; 368: 1575

Evolution of XDR F 15/LAM 4/KZN strain of TB in Kwa. Zulu-Natal, South Africa MDR-TB XDR-TB M. Pullay and AW. Strum, CID 2007; 45: 1409

Countries with XDR-TB confirmed cases (2008. 02, 45 countries) 40, 000 XDR-TB cases emerge every year WHO 2008, http: //www. who. int/tb

동서신의학병원 MDR-/XDR-TB I N H R F P E M B P Z A SM KM AM #1 R R R S S S #2 R R R S S #3 R R S R #4 R R R #5 R R #6 R R (06. 6 ~ 08. 11) CM O F X L F X M F X CS P A S R B T Pto Eto - S S - S R - S S R R R S R - R R - S R R S S - S S R R - S R - R S - S S S S - S S R - - -

우리나라 MDR/XDR TB 치료 성적에 대한 연구 • 다기관 연구 (2000, 1 ~ 2002, 12) – 단국대학교병원 – 결핵연구원 – 마산결핵병원 – 목포결핵병원 – 연세대학교병원 – 한양대학교병원 – 차병원 – 충북대학교병원 – 일산백병원 – 삼성서울병원 – 울산대학교병원 Am J Respir Crit Care Med, 2008

WHO TB Control Strategy • DOTS (Directly Observed Treatment, Short-course) – HREZS (INH, RFP, EMB, PZA, Sm) • Regardless of patient drug-susceptibility pattern • AFB culture & Drug susceptibility test (DST) – May be unavailable

Espinal MA, JAMA, 2000; 283; 2537

• New case • Retreatment case Espinal MA, JAMA, 2000; 283; 2537

Clinical outcome of individualised Tx of MDR TB in Latvia MDR-TB in Latvia 14% of new cases 54% of previously treated cases Lancet 2005; 365: 318

Individualized Treatment of MDR-TB (Latvia) (Leimane et al. Lancet 2005; 365: 318)

Aggressive therapy in MDR-/XDR-TB • 삼성 서울 병원 연구 (1995 ~ 2004) Clin Infect Dis, 2008; 47; 496

觀 點 Confirmative • Bacteriology VS • Radiology Supportive
3db6fb94ea5e9e7878c4a594a0042fe9.ppt